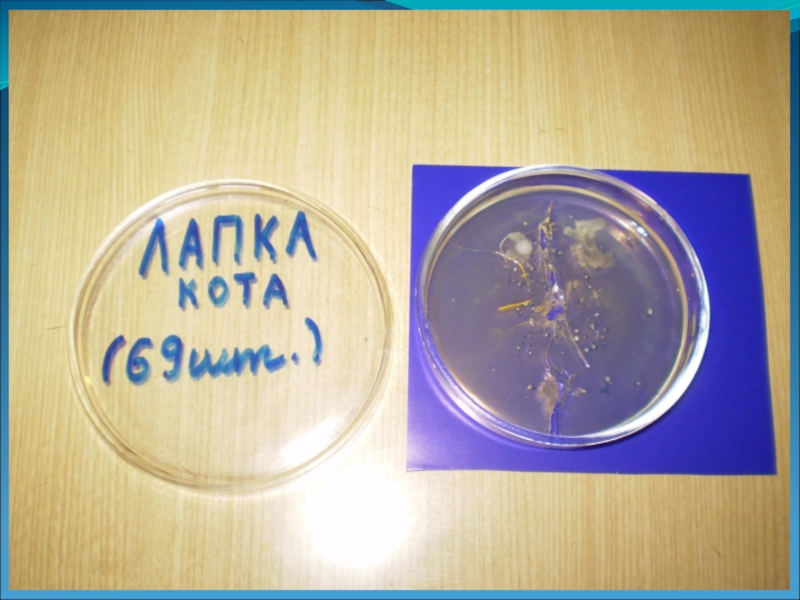
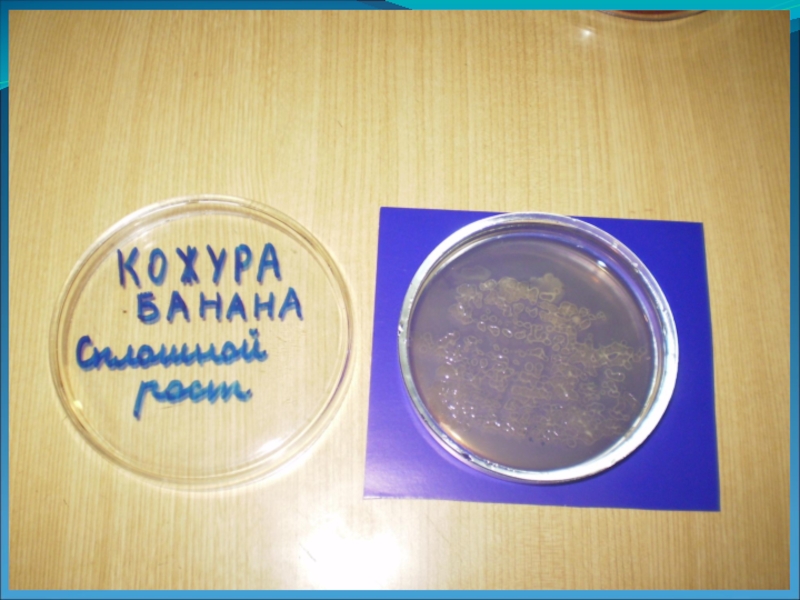

- Главная
- Разное
- Образование
- Спорт
- Естествознание
- Природоведение
- Религиоведение
- Французский язык
- Черчение
- Английский язык
- Астрономия
- Алгебра
- Биология
- География
- Геометрия
- Детские презентации
- Информатика
- История
- Литература
- Математика
- Музыка
- МХК
- Немецкий язык
- ОБЖ
- Обществознание
- Окружающий мир
- Педагогика
- Русский язык
- Технология
- Физика
- Философия
- Химия
- Шаблоны, фоны, картинки для презентаций
- Экология
- Экономика
Презентация, доклад на тему Исследовательская работа по теме Микробы
Содержание
- 1. Исследовательская работа по теме Микробы
- 2. Проблемный вопрос: Какие микробы нас окружают
- 3. ЗАДАЧИ:Нам необходимо выяснить:Есть ли микробы на руках
- 4. ГИПОТЕЗЫ:Я думаю, что на руках есть вредные
- 5. Микробы - это невидимые глазом организмы.
- 6. опыт
- 7. Слайд 7
- 8. Слайд 8
- 9. Слайд 9
- 10. Слайд 10
- 11. Слайд 11
- 12. Слайд 12
- 13. Слайд 13
- 14. Слайд 14
- 15. Слайд 15
- 16. Прошло три дня
- 17. Слайд 17
- 18. Слайд 18
- 19. Слайд 19
- 20. Слайд 20
- 21. Слайд 21
- 22. Слайд 22
- 23. Слайд 23
- 24. Слайд 24
- 25. Слайд 25
- 26. Таблица результатов экспериментаКОККИ – воздушные микробы шарообразной
Проблемный вопрос: Какие микробы нас окружают и все ли они опасны?Цель исследования:Постараться выяснить какие микробы есть у нас на руках и на других предметах.
Слайд 1Микробы
Работу выполнила
ученица 4В класса
МОУ «Лицей»
Смолянинова Анна
Руководитель: Гилёва
Галина Владимировна
2008 г.
Слайд 2 Проблемный вопрос:
Какие микробы нас окружают и все
ли они опасны?
Цель исследования:
Постараться выяснить какие микробы есть у нас на руках и на других предметах.
Слайд 3ЗАДАЧИ:
Нам необходимо выяснить:
Есть ли микробы на руках , и есть ли
среди них вредные микробы, способные вызвать опасные заболевания?
Есть ли микробы на руках, вымытых с мылом?
Сколько микробов на лапке у кота?
Присутствуют ли микробы на кожуре банана?
Есть ли микробы на руках, вымытых с мылом?
Сколько микробов на лапке у кота?
Присутствуют ли микробы на кожуре банана?
Слайд 4ГИПОТЕЗЫ:
Я думаю, что на руках есть вредные микробы, потому что мы
трогаем разные предметы: обувь, дверные ручки, домашних животных, стол, пенал и т.д.
Я думаю, что после мытья с мылом, на руках остаётся намного меньше микробов.
Я думаю, что на лапках кота мало микробов, потому что основную их часть он слизывает языком.
Я думаю, что на кожуре банана немало микробов, потому что он прошёл до нас очень большой путь: сбор бананов, погрузка, разгрузка, руки продавца при выкладывании на прилавок.
Я думаю, что после мытья с мылом, на руках остаётся намного меньше микробов.
Я думаю, что на лапках кота мало микробов, потому что основную их часть он слизывает языком.
Я думаю, что на кожуре банана немало микробов, потому что он прошёл до нас очень большой путь: сбор бананов, погрузка, разгрузка, руки продавца при выкладывании на прилавок.
Слайд 5
Микробы - это невидимые глазом организмы. Их можно увидеть только
в микроскоп. Они везде распространены : в воздухе, в воде, на поверхностях и т.д.
Они очень разнообразны по виду:
Шарообразные - кокки
Палочковидные - палочки
Овальные - дрожжи
Разветвленные - плесени
Среди них есть безвредные и опасные, которые могут вызвать серьезные заболевания.
Они очень разнообразны по виду:
Шарообразные - кокки
Палочковидные - палочки
Овальные - дрожжи
Разветвленные - плесени
Среди них есть безвредные и опасные, которые могут вызвать серьезные заболевания.
Слайд 26Таблица результатов эксперимента
КОККИ – воздушные микробы шарообразной формы ( НЕ ОПАСНЫ
ДЛЯ ЗДОРОВОГО ЧЕЛОВЕКА)
ПАЛОЧКА- микробы, которые присутствуют на грязных поверхностях (МОГУТ БЫТЬ ОПАСНЫ ДЛЯ ЗДОРОВОГО ЧЕЛОВЕКА)
БАКТЕРИИ ГРУППЫ КИШЕЧНОЙ ПАЛОЧКИ- семейство микробов, которые могут вызывать кишечные заболевания (МОГУТ БЫТЬ ОПАСНЫ ДЛЯ ЗДОРОВОГО ЧЕЛОВЕКА)
СПОРОВАЯ ПАЛОЧКА- микробы, которые способны образовывать защитную оболочку. Эта оболочка помогает пережить неблагоприятные условия- засуха, холод и т.д. Попав в благоприятные условия, оболочка раскрывается и микробы могут питаться и размножаться. (МОГУТ БЫТЬ ОПАСНЫ ДЛЯ ЗДОРОВОГО ЧЕЛОВЕКА).
ПАЛОЧКА- микробы, которые присутствуют на грязных поверхностях (МОГУТ БЫТЬ ОПАСНЫ ДЛЯ ЗДОРОВОГО ЧЕЛОВЕКА)
БАКТЕРИИ ГРУППЫ КИШЕЧНОЙ ПАЛОЧКИ- семейство микробов, которые могут вызывать кишечные заболевания (МОГУТ БЫТЬ ОПАСНЫ ДЛЯ ЗДОРОВОГО ЧЕЛОВЕКА)
СПОРОВАЯ ПАЛОЧКА- микробы, которые способны образовывать защитную оболочку. Эта оболочка помогает пережить неблагоприятные условия- засуха, холод и т.д. Попав в благоприятные условия, оболочка раскрывается и микробы могут питаться и размножаться. (МОГУТ БЫТЬ ОПАСНЫ ДЛЯ ЗДОРОВОГО ЧЕЛОВЕКА).